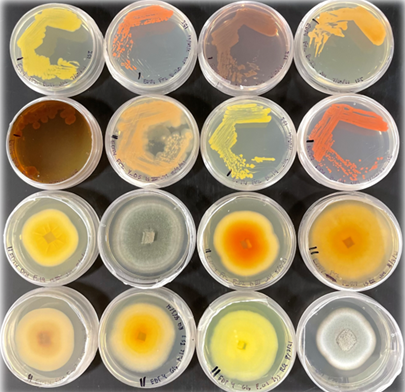

Using microbial solutions to extract critical minerals from industrial waste, creating a sustainable future for resource recovery.
Discover Our Technology
Our Circular Approach
We integrate into the circular economy by transforming industrial waste into valuable resources, minimizing environmental impact while maximizing resource recovery.
Sustainable Technology
Using microbes that consume charcoal to extract critical minerals from industrial waste. Our AI-driven synthetic biology approach harnesses the genetic potential of microbes for enhanced bioleaching capabilities.

Critical Minerals
Extracting Rare Earth Elements from waste streams to stabilize supply chains and reduce market volatility in critical mineral markets.


Waste Management
Processing Li battery waste, coal fly ash, red mud, and mine tailings. Our innovative process reduces waste volume by up to 90%, significantly minimizing environmental impact.
Partner with us to transform waste management and secure critical minerals sustainably.